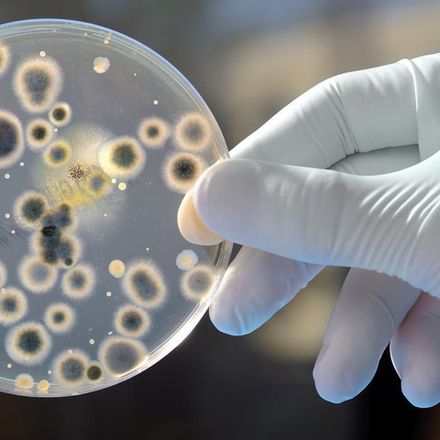
Грибковые инфекции

Протоколы

Волосы

Учеба в школе

Weight loss peptides support

Антипаразитарные Препараты

Синдром Беспокойных Ног

Клостридии

Женское здоровье

Органопрепараты

Настроение

SIBO / СИБР

Аутизм - стартовый набор
Грибковые инфекции

Поддержка щитовидной железы

Хеликобактер пилори

Иммунитет

Антивирусные добавки

Митохондриальная поддержка

Речь и коммуникация

Кости и суставы

Сон

Антистресс

Волосы, кожа, ногти

Мужское здоровье

PANDAS

Долголетие

Контроль веса

Минералы

Витамины группы В

Когнитивные функции

От простуды

Аллергия

Синусит

Детокс организма

Детское здоровье

Хелатирование

Кето

Кишечник

Поддержка печени

Ancestral Supplements
В данном разделе пока нет товаров. Мы работаем над этим.
Специально подобранные наборы добавок в соответствии с протоколами коррекции.

